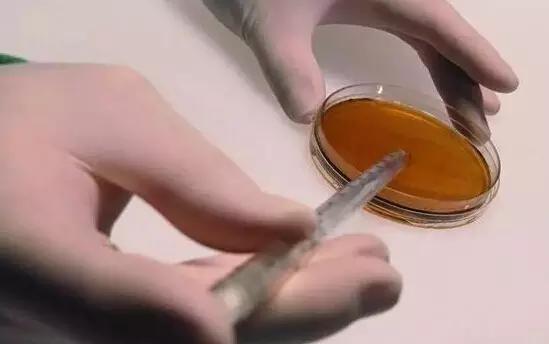

假定2012年是生物刺激素发展史上的元年,那么今年应该是生物刺激素第六年,元年前,很多生物刺激素类的产品早就在中国推广并使用了。那时中国老百姓的俗称是叶面肥,科学界的几个专家一致并且一直称之为“功能性肥料”。很多老百姓都知道叶面肥好,打上去能够增产。但是就是价格有点高,他们中很多人并不去算自己的投入产出比的明细账。不可否认,农户中还是有相当大的群体对于自己的收入和投入有着非常明确的计算。其中最著名的国内品牌是“生命素”。这个产品曾经遍布全国各个角落。商学院的MBA们应该好好研究它的兴衰历史。无论如何,中国农资业在这个方面的探索并没有比世界水平落后多少。甚至不客气的说,我们应该比其他一些国家的商品化过程要更早一些。虽然植物生物刺激素在中国农业投入品类里面至今没有一个十分明确的归属地位和管理条例。可是目前最先进的欧盟也是正在沿着我们土壤肥料科学管理中心所指引的路线前进。未来植物生物刺激素归属于肥料管理范畴。

元年之前,英国人称生物刺激素为“神奇的垃圾”。美国人叫它“蛇油”,巴西人的称呼最有意思“土豆水“,我们不了解这个名次的含义,但是可以肯定这一定不是一个大家都认可的褒义词。所以看起来,中国人的称呼更文明一些。好歹我们也是一个历史悠久的文明社会。
时光进入元年之后,植物生物刺激素在欧洲似乎是得到了佛祖的开光一样。突然就开始红火起来。那个欧洲生物刺激素生产企业联盟最初成立时只有14家企业。目前已经有53家之多了。不仅仅是企业开始重视,批发及零售的供应商也开始重视这个小娃娃。自己有了热点,资本就要开始流动,人才也要开始流动。十多年前,还有国际著名的德国农药巨头曾试图完全停止生物刺激素的开发和研究呢。现在呢高级经理也开始在国际会议上奢谈生物刺激素的开发了。

确实,在世界农业生产实践中,生物刺激素类产品的表现不那么稳定。甚至不那么突出。这些现象都是人们在习惯施用化学制剂之后的对生物制剂产品的一种普遍看法。首先生物刺激素是一大类产品,不是几个单一的产品所组成。一个产品不论其表现好坏如何,都不能代表生物刺激素的好坏。就是同一小类的生物刺激素,生产原料来源不同的生产商所提供的产品在田间便显得也肯定是不一样的。就拿海藻提取物(中国俗称海藻肥)类产品来说,其中的变化就非常多。制剂产品中可以添加好多因素,例如矿质元素,腐植酸等成分。即便是单一海藻提取物的制剂,其中活性成分也不一定完全一样。所以使用时就需要花费大量的时间和金钱去研究。可是世界上主要的生产供应商大多数是一些小或微型企业。
生物刺激素六年之后,很多大跨国公司开始介入了。而且哪些小公司因为资本介入也从大家伙那边吸引了一部分人才。科学界的投入也是越来越多了。所以更多的活性成分,作用机理一定会得到更多的理解。
但是还有个问题需要得到大家的注意,就是小厂商因为资金和人力不足,他们的新产品在推广时会遇到很多的问题。并不是他们的产品不好,只是他们没有更多的实力去完成初期的数据积累。相反目前大的跨国巨头推出的产品则往往不是他们的亲生孩子,或多或少会有一部分夹生饭。因此大家要充分重视小生产厂商的优秀产品。一定不要错过好机会。
产品的好坏目前不能完全看其成分构成。原因有两个,第一是全球的研究都没有完全深入的水平,第二这些产品往往都是多种活性或有益成分的混合体。所以在面对新产品的选择时,不能完全听销售人员的许诺。而是要看其田间的表现是否和他的许诺相一致。仅仅一个表现就可以推到全局了。在现阶段也只有这样了,因为你没有时间等他拿出全套的数据。如果他能够拿出完整的数据时,或许原本是你的机会早已是别人的碟中菜了。

产量增加是农户追求的目标。生物刺激类产品可以帮助种植户解决10-20%左右的产量构成能力。但是一旦遇到胁迫,生物刺激素就是您减少损失的必备良器。敌人不来时,兵器可以放南山。敌人来也,生物刺激素就是抵御之必备。
对于我们国人来讲,生物刺激素类产品往往在改善农产品品质方面还有非常明显的差别。我们在果树上也曾体验到这种改变在年度间的积累。如何证明农产品品质的改善对全世界来讲还是一个难题。特别口感和风味的变化。同样,这些资料的积累需要有充足的资金支持。
尽管生物刺激素类产品的推广进入了一个新的阶段,所有的产品要开始比拼其效果的高低了。其实这也就是说大家要开始关注作物的功能性需求了。因为最好的效果一定是由最佳的施用方法和使用剂量所综合的结果。农资人应该更多的关注产品的效果,当然我们也在等待更多作用机理的揭晓。
